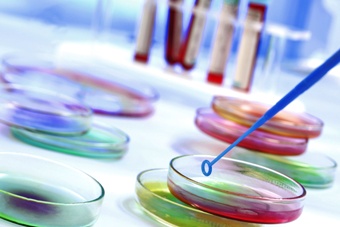

-
Téléphone : 043 423 847
-
e-mail : contact@smartchim.dz
Produits
Produits
Produits chimiques
Dans la section Chimie, nous vous proposons les produits chimiques que vous utilisez couramment lors de vos travaux pratiques.
- Produits Chimiques d’Usage Général
- Réactifs et Solvants pour Analyse
- Colorants et indicateurs
- Solutions pour Titration
- Produits de Microbiologie, Biologie Moléculaire, Culture Cellulaire
- Solvants pour Chromatographie